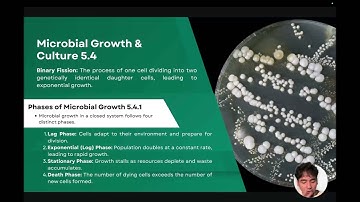
BIO101-1 1T2526 A12 Microbial Biotechnology (Part 2: Microbial Metabolism)

⬇ DOWNLOAD NOW
Kalau muncul iklan pop-up, tutup lalu klik tombol kembali
Download lagu BIO101-1 1T2526 A12 Microbial Biotechnology (Part 1: Introduction) secara gratis hanya untuk keperluan promosi. Dukung artis favorit kamu dengan membeli musik original di iTunes atau platform resmi lainnya.
 BIO101-1 1T2526 A12 Nanobiotechnology (Part 1)
BIO101-1 1T2526 A12 Nanobiotechnology (Part 1)
 BIO101 1 3T2425 A12 Industrial Biotechnology (Part 1: Introduction)
BIO101 1 3T2425 A12 Industrial Biotechnology (Part 1: Introduction)
 BIO101-1 1T2526 A12 Microbial Biotechnology (Part 5: Food Microbiology)
BIO101-1 1T2526 A12 Microbial Biotechnology (Part 5: Food Microbiology)
 BIO101-1 1T2526 A11 Medical Biotechnology
BIO101-1 1T2526 A11 Medical Biotechnology
BIO101-1 1T2526 A12 Microbial Biotechnology (Part 2: Microbial Metabolism)
BIO101-1 1T2526 A12 Microbial Biotechnology (Part 2: Microbial Metabolism)
 BIO101-1 1T2526 A12 Microbial Biotechnology (Part 3: Genetic Recombination in Bacteria)
BIO101-1 1T2526 A12 Microbial Biotechnology (Part 3: Genetic Recombination in Bacteria)
 Animal Biotechnology (Part 1: Introduction) | BIO101-1 1T2526 A11 Group 7
Animal Biotechnology (Part 1: Introduction) | BIO101-1 1T2526 A11 Group 7
 BIO101-1 1T2526 A12 Microbial Biotechnology (Part 4: Use of E. Coli in Microbial Cloning)
BIO101-1 1T2526 A12 Microbial Biotechnology (Part 4: Use of E. Coli in Microbial Cloning)